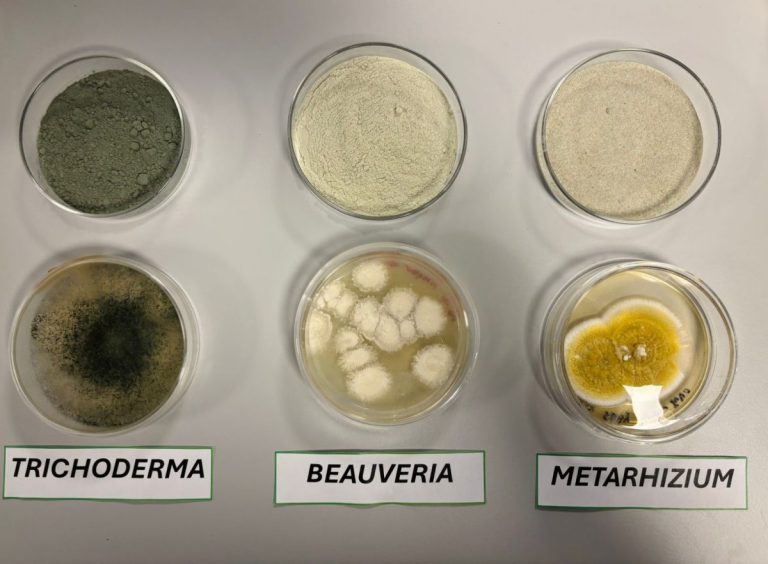

NS Group Holding biotecnología, alianzas y visión global para una agricultura sostenible
Desde una de las plantas más modernas de Latinoamérica, NS Group Holding impulsa soluciones innovadoras en nutrición vegetal y bioinsumos. Con presencia en Chile, Perú y EE.UU., y planes de expansión hacia 2026, la compañía apuesta por la investigación, las alianzas estratégicas y un modelo de negocio enfocado en sostenibilidad y colaboración.
En el corazón de la agricultura moderna, NS Group Holding se consolida como un líder en la producción de bioinsumos y soluciones de nutrición vegetal de alta tecnología.
Su firme compromiso con la sostenibilidad y la innovación le ha permitido posicionarse como un referente en el sector agrícola, ofreciendo productos que no solo elevan la productividad, sino que también promueven prácticas responsables y respetuosas con el medio ambiente.
Recientemente, Redagrícola tuvo la oportunidad de visitar la planta de producción de NS Group, reconocida como una de las más modernas de Latinoamérica en el desarrollo y producción de bioestimulantes y bioinsumos.
Durante el recorrido, se entrevistó a dos figuras claves de la compañía: Manuel Calvo, CEO, e Isabel Fuentes, CFO, quienes compartieron su visión sobre el futuro de la agricultura y el rol protagónico que NS Group está llamado a desempeñar en ese escenario.
“En NS Group Holding, nuestra pasión por la agricultura sostenible nos impulsa a innovar y desarrollar soluciones que transformen el sector agrícola”, comenta vía videollamada el CEO Manuel Calvo desde su oficina en Miami.
“Creemos en el poder de la biotecnología para generar un impacto positivo en el medio ambiente y en la productividad de nuestros agricultores. Nuestro compromiso es ofrecer productos de calidad y seguridad, siempre alineados con una línea verde sustentable”, agrega.

PLAN DE INVERSIÓN PARA EL FUTURO
Por su parte, Isabel Fuentes, CFO de la compañía, compartió detalles sobre el ambicioso plan de inversión de la empresa. “Estamos proyectando una expansión de nuestras instalaciones para 2026, con una inversión de US$8,4 millones. Esto no solo aumentará nuestra capacidad de producción, sino que también nos permitirá profundizar en la investigación de nuevos productos”, afirma con entusiasmo.
“Nuestra experiencia y crecimiento constante nos han preparado para enfrentar nuevos desafíos a nivel global”, indica.
Con una sólida presencia en el mercado chileno y una creciente expansión en América Latina y los Estados Unidos, NS Group Holding se ha consolidado como un actor clave en la industria agrícola. A través de sus empresas asociadas, Nutrifert Chile, Agromega Perú y NS Group Biosciences LLC en EE. UU., la compañía ha establecido una red de colaboración que le permite ofrecer productos de alta calidad a clientes en todo el mundo.
BÚSQUEDA DE ALIANZAS ESTRATÉGICAS
La innovación y el crecimiento sostenido son pilares fundamentales para NS Group Holding. Isabel nos comenta sobre las recientes alianzas estratégicas que han permitido obtener nuevos registros de marca en Brasil y México.
“Estas oportunidades abren nuevas puertas en el mercado internacional, superando nuestras expectativas iniciales. Buscamos establecer acuerdos comerciales que incluyan representación, joint ventures, inversiones y otras colaboraciones estratégicas”, explica.
Las instalaciones de NS Group Holding, que abarcan más de 10,000 m², están equipadas con laboratorios, biorreactores y salas de producción de última generación. Un equipo pro- fesional altamente capacitado asegura la calidad, seguridad e inocuidad de cada producto. “Nos regimos por estándares rigurosos en nuestros procesos de fabricación, utilizando biotecnología, biofermentación, nanotecnología, y más, para garantizar la excelencia de nuestros insumos”, añade Isabel con orgullo.
Productos innovadores con valor agregado
NS Group Holding ofrece una amplia gama de productos de valor agregado, centrados en soluciones biológicas para el control y prevención de enfermedades en cultivos. Entre sus innovaciones se encuentran formulaciones de bioinsumos en presentaciones WP (polvo mojable) y SL (suspensiones líquidas), así como bioestimulantes compuestos.
Los bioestimulantes ayudan a fortalecer las plantas, mejorando su resistencia a enfermedades y condiciones adversas, lo que a su vez beneficia el medio ambiente al reducir la necesidad de insumos químicos. Por otro lado, las soluciones biológicas proporcionan un enfoque integral para el manejo de cultivos, fomentando un ecosistema más saludable y equilibrado.
“Nuestros productos están diseñados para maximizar el rendimiento agrícola mientras cuidamos del entorno”, explica Manuel Calvo.
RELACIONES COMERCIALES A LARGO PLAZO
En cuanto a los productos biológicos, NS Group Holding establece acuerdos comerciales a largo plazo que fomentan el apoyo mutuo entre las compañías. “Este enfoque colaborativo no solo fortalece nuestras relaciones comerciales, sino que también contribuye al desarrollo sostenible de la agricultura”, destaca Isabel.
La misión de NS Group Holding es clara: desarrollar y producir bioinsumos y soluciones de nutrición vegetal que aporten valor agregado a la agricultura. A través de la investigación y la innovación, la empresa busca mejorar la eficiencia y la rentabilidad de sus clientes, garantizando al mismo tiempo la salud del ecosistema.
Su visión se centra en ser líderes en el desarrollo de bioinsumos y nutrición vegetal a nivel internacional, estableciendo un modelo de negocio que potencie la colaboración y el crecimiento sostenible.
Por lo expuesto, NS Group Holding se posiciona como un líder en la industria agrícola, comprometido con la innovación, la sostenibilidad y la calidad. Con un enfoque en la colaboración y el crecimiento, la empresa está lista para enfrentar los desafíos del futuro y seguir marcando la pauta en el desarrollo de soluciones agrícolas efectivas y responsables.
